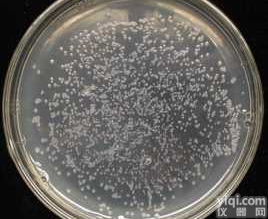
ATCC <em>25922</em> <em>大肠</em>埃希氏菌(<em>大肠</em>杆菌)

上海远慕生物专业供应抗生素、维生素、培养基、染色剂、酶/辅酶、碳水化合物、分离试剂、缓冲试剂、核酸及衍生物、氨基酸/蛋白质等其它生化试剂。品质保证,货源充足。各种包装规格,并可提供包装定制,欢迎来电咨询。
产品名称:P1543/ATCC25922大肠埃希菌
供应商:远慕生物
抗性:Kan
培养基:YEB
菌株类别:农杆菌
培养条件:28℃,有氧,YEB
质粒转化:电转、化转
保存方式:30%甘油,-20℃
基本应用:转基因
菌株简介:
A4发根农杆菌是一种天然农杆碱性农杆菌,菌株本身均有卡那霉素Kan(50ug/ml)的抗性,可在YEB或LB培养基上进行培养,培养的Z适温度为28℃,A4农杆菌是耗氧型,通常使用30%的甘油保藏菌种。
YEB培养基(1L):牛肉浸膏5g,酵母浸膏1g,蛋白胨5g,蔗糖5g,MgSO4·H2O0.5g,用NaOH调整PH至7.0。
P1543/ATCC25922大肠埃希菌 质粒分类:
1.根据质粒能否通过细菌的接合作用,可分为接合性质粒和非接合性质粒。接合性质粒带有与接合传递有关的基因。非接合质粒在一定条件下通过与其共存的接合质粒的诱动或转导而传递。
2.根据质粒的不相容性,可分为不相容性和相容性。不相容性指结构相似、密切相关的质粒不能稳定地共存于同一宿主细菌内的现象,反之为相容性。常用于流行病学的调查。
3.根据质粒在细菌内的复制类型可分为两类:严紧控制型和松弛控制型。严紧控制复制型质粒的复制酶系与染色体DNA复制共用,只能在细胞周期的一定阶段进行复制,当细胞染色体停止复制时,质粒也就不再复制。松弛控制复制型的质粒的复制酶系不受染色体DNA复制酶系的影响,在整个细胞生长周期中随时都可以复制,在染色体复制已经停止时质粒仍能继续复制。
P1543/ATCC25922大肠埃希菌 产品简介:
质粒(plasmid)是细菌或细胞染色质以外的,能自主复制的,与细菌或细胞共生的遗传成,质粒载体是在天然质粒的基础上为适应实验室操作而进行人工构建的质粒。与天然质粒相比,质粒载体通常带有一个或一个以上的选择性标记基因(如抗生素抗性基因)和一个人工合成的含有多个限制性内切酶识别位点的多克隆位点序列,并去掉了大部分非必需序列,使分子量尽可能减少,以便于基因工程操作。
产品特点:
1. 国内对照品行业,长达14年对照品的专业研发及标准制定
2. GX稳定的纯化技术-高速逆流色谱技术的运用
3. 特有的高速逆流色谱对照品研发ZX及生产ZX,保证对照品的质量可控性及批量生产的稳定性
4. 严格的质量控制,通过全面的检测(1HNMR 13CNMR MS HPLC)
5. 部分对照品已获得国家质量监督检验检疫总局颁发的标准物质证书
6. 完善的库存及供应体系,所有产品均能现货供应
7. GX的销售团队,99%的咨询可即时回复
订购流程
1、绝大部分产品备有现货,一般情况下都能订货当日发货。
2、部分非常用产品,需提前1-2日预订,海外期货则需要提前3-6周预订。
3、部分产品价格会因货期、批次等因素发生变化,若有变动以订货当日价格为准。
4、每日订单截止时间为16点整,部分城市可到17点整,因超过截止时间造成当日不能发货的将于次日安排发货。
相关产品:
P1499/Tuner(DE3)大肠表达菌
P1500/Tuner(DE3) pLysS大肠表达菌
P1501/K802大肠杆菌
P1502/HT115(DE3)①大肠杆菌
P1503/HT115(DE3)②大肠杆菌
P1504/GS115毕赤酵母菌
P1505/GS115-Zeo毕赤酵母菌
P1506/X33毕赤酵母菌
P1508/KM71H毕赤酵母菌
P1507/KM71毕赤酵母菌
P1509/SMD1168毕赤酵母菌
P1523/PichiaPink-1毕赤酵母菌
P1522/PichiaPink-4毕赤酵母菌
P1762/INVSC1①酿酒酵母菌
P1510/INVSC1②酿酒酵母菌
P1511/BY4741酿酒酵母菌
P1512/BY4742酿酒酵母菌
P1513/ATCC9080酿酒酵母菌
P1514/EBY100酿酒酵母展示菌
P1520/Y1HGold酵母单杂交菌